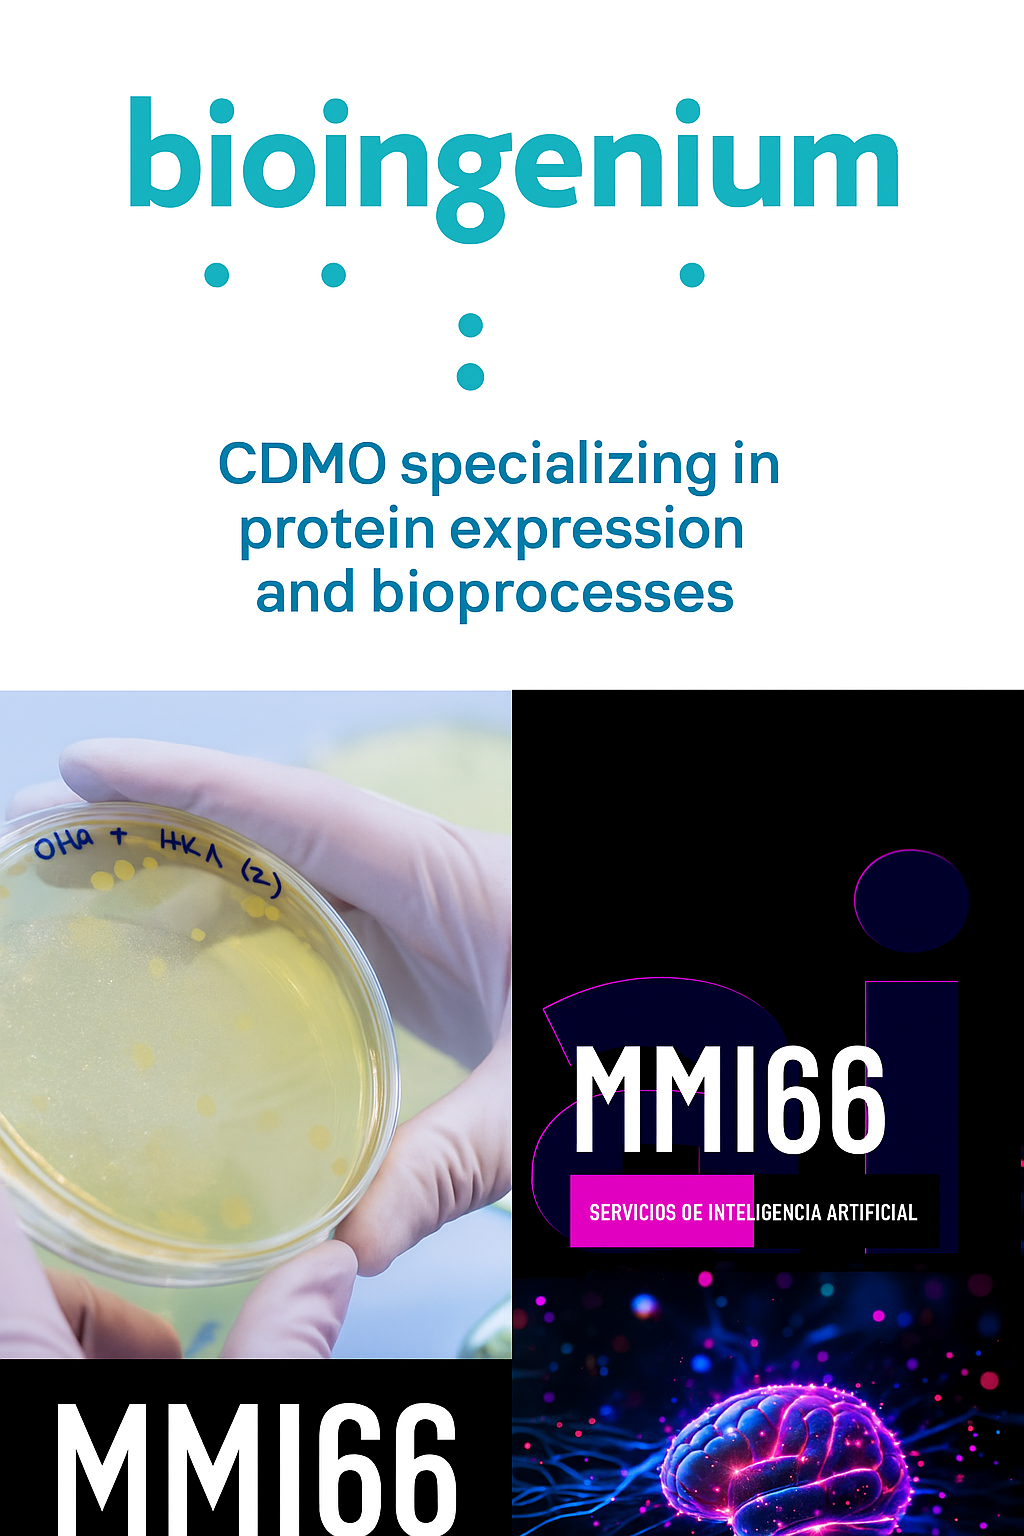

CDMO especialista en expresión de proteínas y bioprocesos
Bioingenium y la IA de MMI66 · MAG Market Intelligence
Bioingenium es una CDMO biotecnológica con sede en Barcelona que desarrolla y escala bioprocesos para producir proteínas recombinantes en fase preclínica, trabajando con sistemas bacterianos, de levadura y células de mamífero. Con más de 15 años de experiencia y presencia en más de 20 países, ha colaborado con más de 150 compañías biotecnológicas, biofarmacéuticas y cosméticas, acompañando proyectos desde la prueba de concepto hasta la transferencia a planta GMP.bioingenium+1
Sus plataformas tecnológicas cubren las principales vías de expresión: E. coli para proteínas de menor complejidad y alto rendimiento; Pichia pastoris para secreción y modificaciones como puentes disulfuro; y líneas de mamífero (CHO/HEK) para proteínas complejas y de calidad clínica. La compañía diseña y optimiza procesos upstream y downstream, desarrolla cepas y líneas celulares, y entrega lotes purificados con certificados de análisis, incluida la eliminación/análisis de endotoxinas cuando procede. Bajo certificación ISO9001:2015, Bioingenium prioriza la seguridad y la reproducibilidad, con gestión rigurosa de proyectos y equipos y equipamiento apropiados.bioingenium+3
Entre sus capacidades destacan: síntesis y clonación génica, producción a escala de miligramos a gramos, diseño de procesos de purificación a ≥90% de pureza, análisis por SDS‑PAGE, Western Blot, SEC‑MALS y MS, además de escalado en biorreactores y producción de batches preclínicos. Su oferta se extiende a antígenos y proteínas para IVD, enzimas para terapias génicas y vacunas mRNA, y fermentación de precisión para ingredientes alimentarios y cosméticos. Bioingenium está inmersa en un plan de expansión de instalaciones en el Parc Científic de Barcelona para reforzar su capacidad de I+D y proyección internacional.linkedin+5
- Enlaces externos: Bioingenium (home y plataformas); Plataforma bacteriana y entregables; Pichia pastoris y expertise.bioingenium+2
- Enlace interno: Contacto MMI66/MAG Market Intelligence: https://magmarketintelligence.com/contacto/
La IA de MMI66 · MAG Market Intelligence puede acelerar a Bioingenium con priorización de carteras, inteligencia competitiva, scoring de leads y automatización de propuestas técnicas reguladas, impulsando eficiencia comercial y time‑to‑milestone.bioingenium+2
- https://www.bioingenium.net
- https://www.bioingenium.net/our-expertise/
- https://www.bioingenium.net/technology-platforms-bacterial-expression/
- https://www.bioingenium.net/technology-platforms-pichia-pastoris/
- https://www.bioingenium.net/cdmo-services-cell-line-development/
- https://es.linkedin.com/company/bioingenium-s-l-
- https://www.pcb.ub.edu/en/bioingenium-expands-rd-facilities-in-the-barcelona-science-park/
- https://www.bioingenium.net/food/
- https://www.bioingenium.net/biopharmaceutical/
- https://www.bioingenium.net/team/
- https://www.asebio.com/socios/directorio/bioingenium
- https://convention.bio.org/exhibitors/bioingenium-sl
- https://www.bioingenium.net/contact/
- https://empresite.eleconomista.es/BIOINGENIUM.html
- https://pmc.ncbi.nlm.nih.gov/articles/PMC8421613/
- https://www.bioingenium.net/about-us/
- https://www.bioingenium.net/llms.txt
- https://www.pcb.ub.edu/es/bioingenium-invierte-15-me-en-una-nueva-planta-de-produccion/
- https://www.asebio.com/en/members/directory/bioingenium
- https://www.bioingenium.net/streptolysin-o-slo/